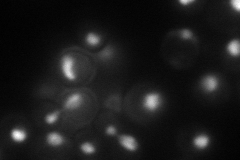
YBR112C
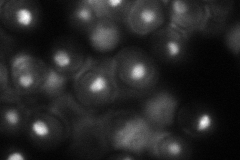
YBR112C

View description
General transcriptional co-repressor, acts together with Tup1p; also acts as part of a transcriptional co-activator complex that recruits the SWI/SNF and SAGA complexes to promoters; can form the prion [OCT+]
Localization:
Intensity:
Fold change:
Significance:
-
C’ GFP library in SD

nucleus50.16 -
N' NOP1pr-GFP in SD
nucleolus76.9822 -
N' TEF2pr-mCherry in SD

nucleus70.2694 -
N' NATIVEpr-GFP in SD
nucleolus66.6987 -
N' TEF2pr-VC and Cyto-VN in SD

#N/A0 -
C’ GFP library in SD+DTT

nucleusN/AN/ANo -
C’ GFP library in SD+H2O2

nucleusN/AN/ANo -
C’ GFP library in Starvation Media

nucleusN/AN/AYes -
C’ GFP library on the background of Pup2-DaMP

nucleus -
C’ GFP library on the background of CCT mutant

nucleusN/AN/ANo
